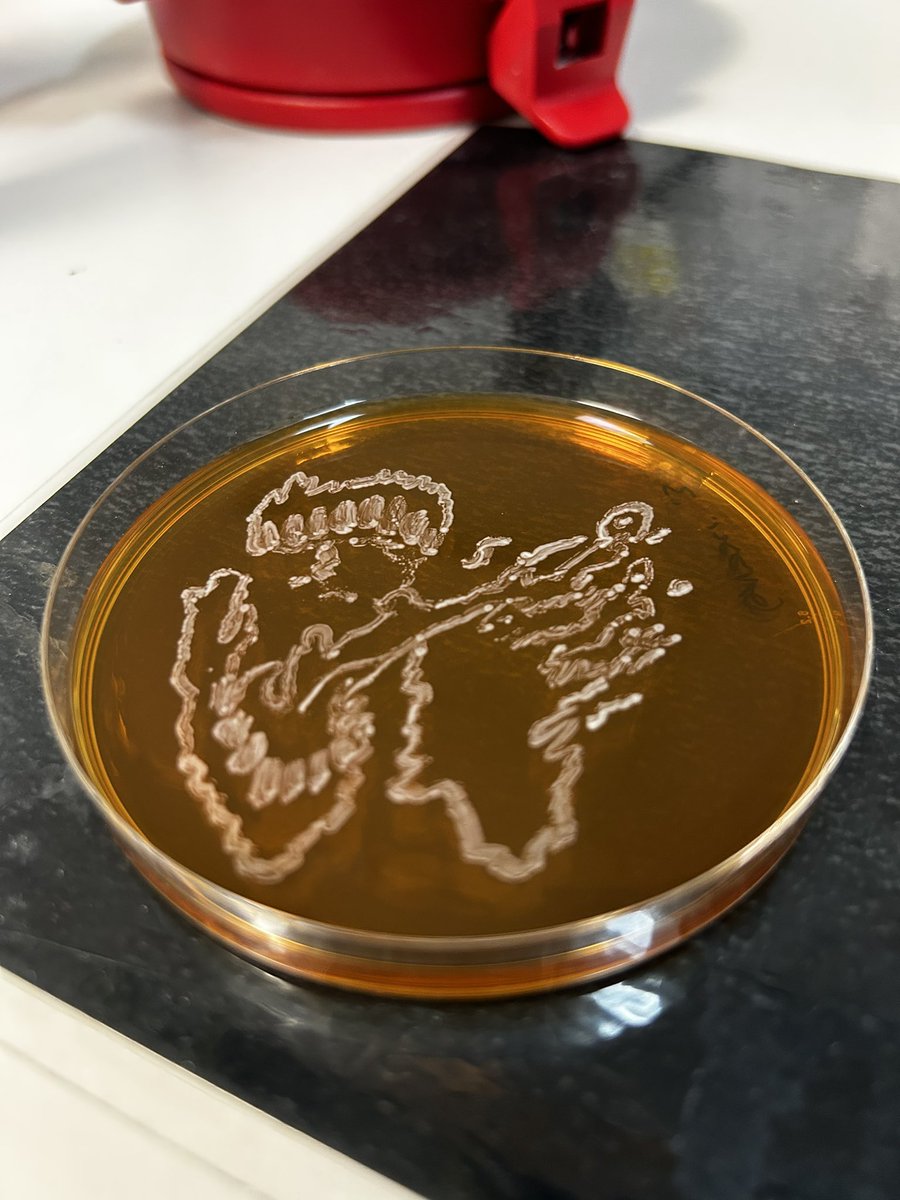
MoosForNow's tweet image. This was the last time i try to draw people. 
Details below as always
#DrawJames

Moos🦔🍉
@MoosForNow
Queue cookie baker ~ Crown crew🫶🏻 ~ microbiology artist ~ very Dutch
She/her 22
Aangemeld in februari 2016
Dit vind je misschien leuk
Vastgezet
This was the last time i try to draw people. Details below as always #DrawJames

7
10
142
3
4K
Moos🦔🍉 heeft deze post opnieuw geplaatst
Brighton headline show on December 3rd! Can’t wait to play some new songs and put on a SHOW for you. Hope to see you there💖 tickets on sale NOW ✨wegottickets.com/event/639405 ✨✨✨

2
5
17
0
584
Got extra 2 t!ckets for goodkid amsterdam tonight if anyone is interested
0
0
0
0
139
Checking mid moshpit if my health insurance will even work in another country
0
0
1
0
80
Shoutout to this dude who is watching the rock werchter livestream om his laptop while sitting in front of the main stage at rock werchter

0
0
1
0
199
Watching f1 and the kooks at the same time was actually really cool haha
0
0
0
0
67
United States Trends
- 1. Nobel Peace Prize N/A
- 2. Machado N/A
- 3. Anthony Black N/A
- 4. Kathleen Kennedy N/A
- 5. Lucasfilm N/A
- 6. Dave Filoni N/A
- 7. Leon N/A
- 8. Karoline N/A
- 9. Insurrection Act N/A
- 10. Board of Peace N/A
- 11. Drew Lock N/A
- 12. New World Order N/A
- 13. Chara N/A
- 14. #ResidentEvilRequiem N/A
- 15. #ImNotGettingOldImGetting N/A
- 16. Uncle Steve N/A
- 17. Azzi N/A
- 18. Lara Croft N/A
- 19. #BigZ33 N/A
- 20. The GitHub N/A
Dit vind je misschien leuk
-
 ju
ju
@fixonsuho -
 lauren🎗
lauren🎗
@raccoonsimons -
 saige .ᐟ ia
saige .ᐟ ia
@SaigeNeverDies -
 eljay
eljay
@louijuliet -
 scarlett/jo 🦢 | SEEING XLOV VIP‼️‼️
scarlett/jo 🦢 | SEEING XLOV VIP‼️‼️
@SCARSVISION -
 becca🩷
becca🩷
@AWTYbecca -
 aphres🏛️²⁹
aphres🏛️²⁹
@felslove -
 .
.
@filler6789 -
 juno
juno
@brickshagger -
 Elodie ☆
Elodie ☆
@YesItsElodie -
 ☆☆wednesday
☆☆wednesday
@mycarlightsup -
 clem
clem
@miaclemeverett -
 ☆ Daz / Jay ☆
☆ Daz / Jay ☆
@futiledaz -
 AST ✪
AST ✪
@aster_is_tall -
 casey becker
casey becker
@dykedelic01
Loading...
Something went wrong.
Something went wrong.
















































































































